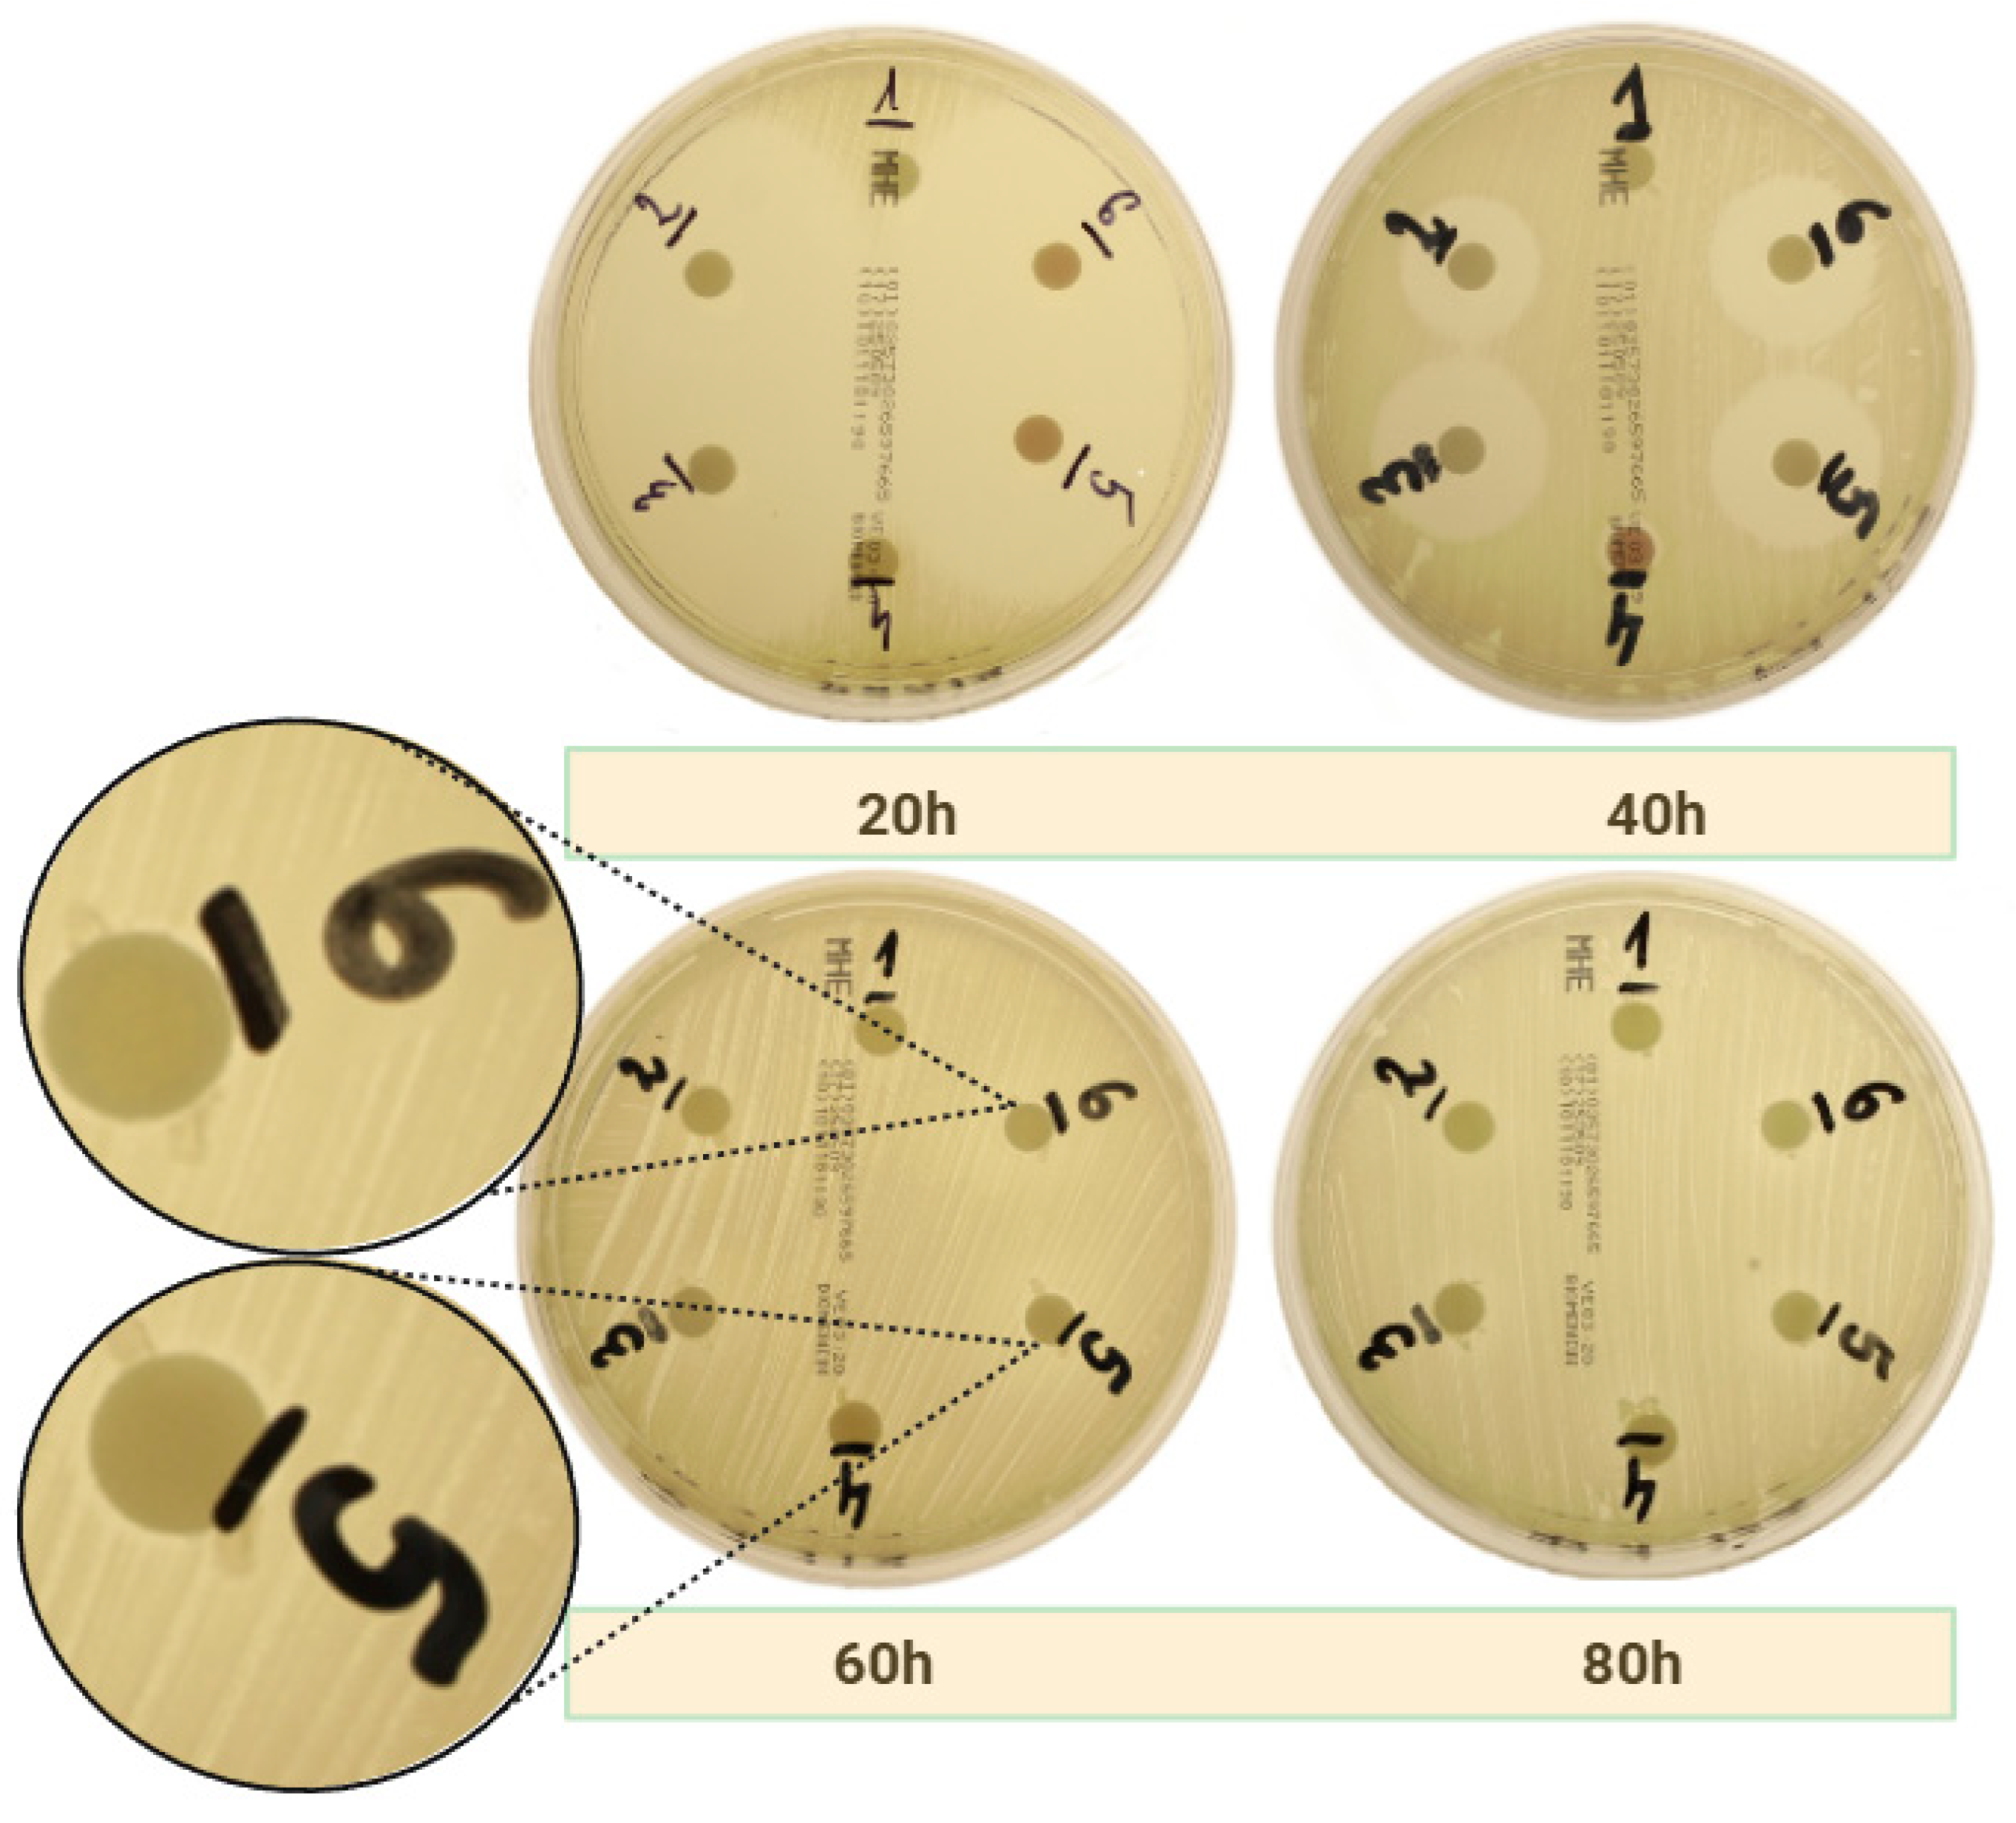
Ijms 26 04303 g001
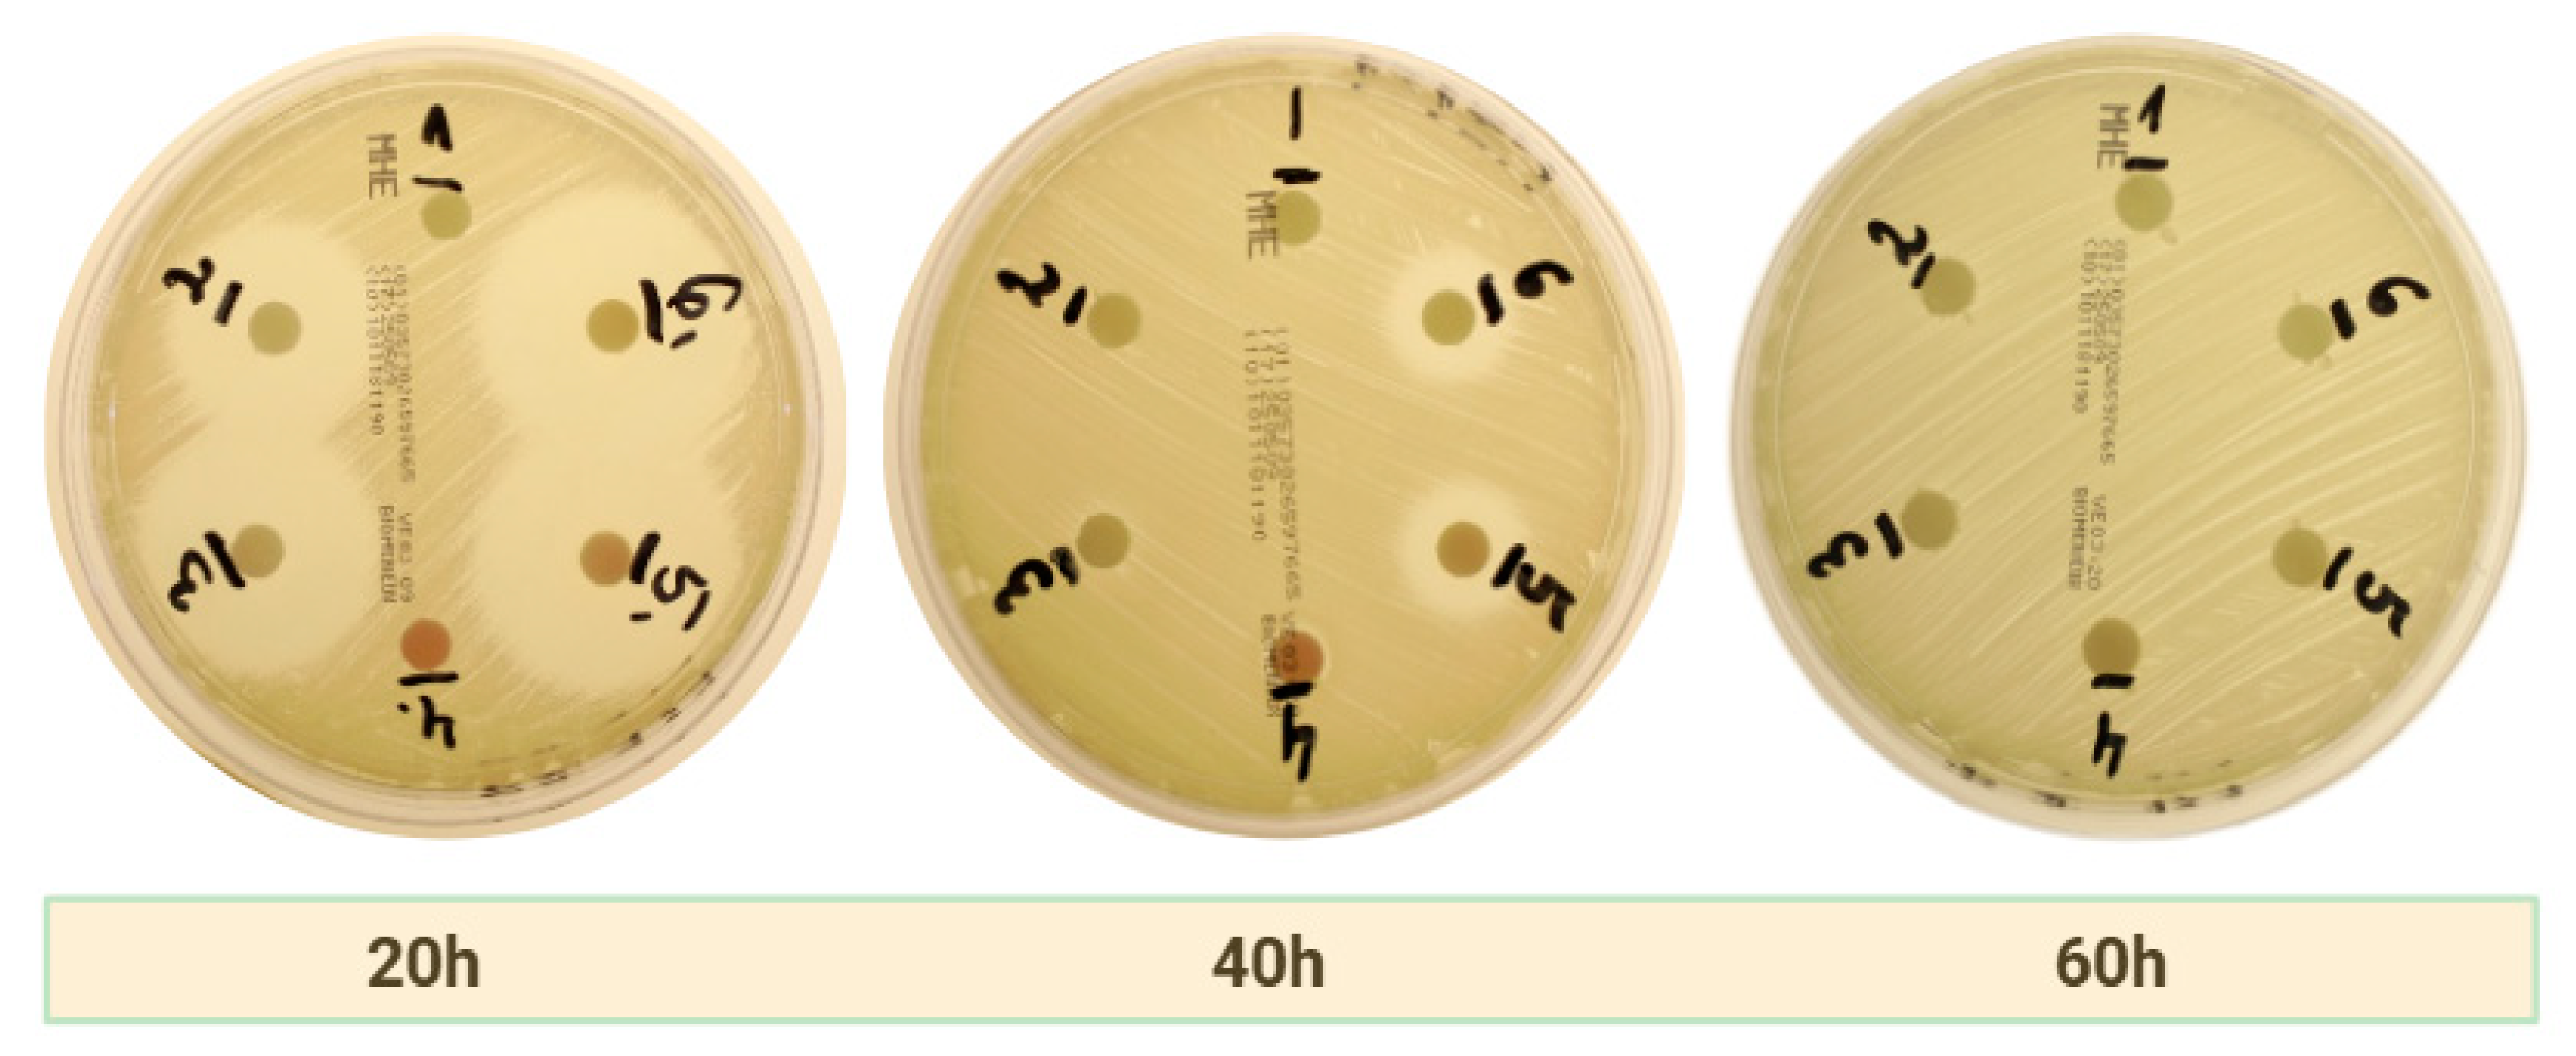
Ijms 26 04303 g002
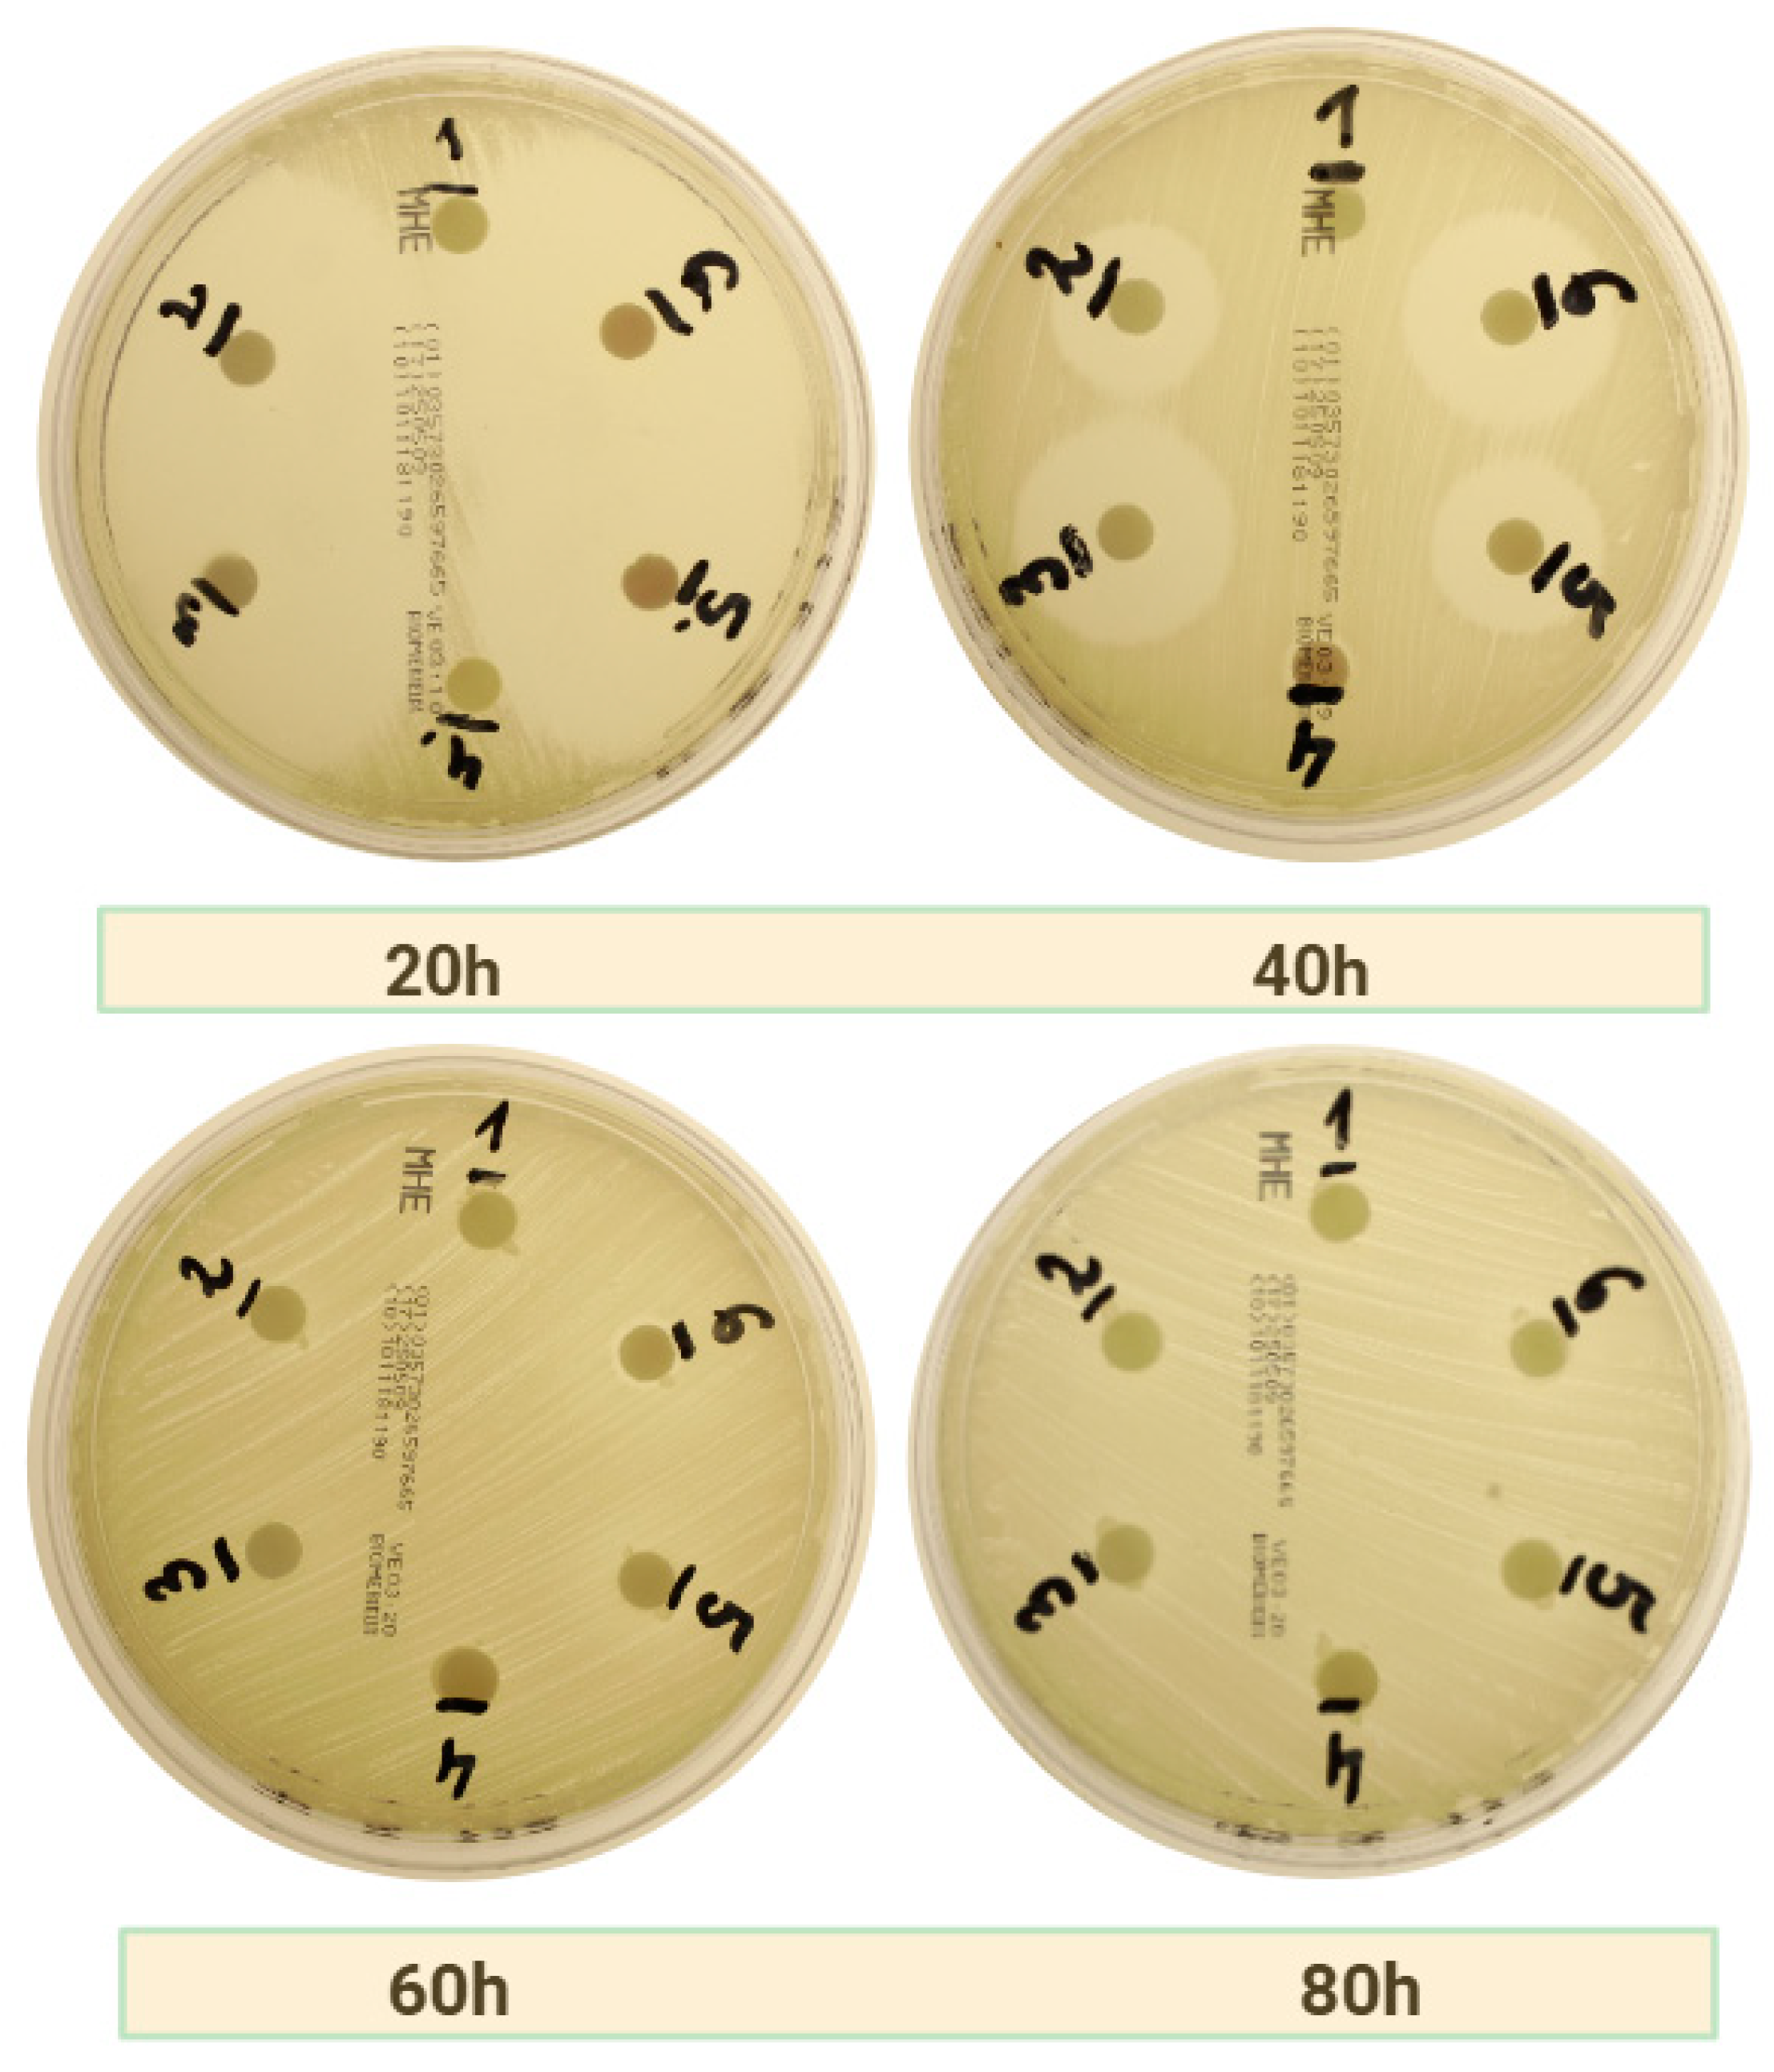
Ijms 26 04303 g003

Comparative Evaluation of Platelet-Rich Fibrin (PRF) and Concentrated Growth Factor (CGF) as Carriers for Antibiotics—In Vitro Study
Abstract
1. Introduction
2. Results
2.1. Clot Formation After Antibiotics Addition
2.2. Antibacterial Effect of APC as Carries for Drugs
2.2.1. Amoxicillin
2.2.2. Clindamycin
2.2.3. Amoxicillin with Metronidazole
3. Discussion
3.1. General Results
3.2. Limitations
3.3. Future Implications
3.3.1. Osteonecrosis of the Jaw
3.3.2. Periodontitis and Periimplantitis
3.3.3. Tooth Extraction
3.3.4. Sticky Bone
4. Materials and Methods
4.1. Population and Study Design
4.2. APC Preparation
4.3. AL-PRF Preparation
4.4. Study Groups
4.5. Bacterial Strains
4.6. Microbiological Analysis
4.7. Measurement of Inhibition Zones
4.8. Statistical Analysis
5. Conclusions
Author Contributions
Funding
Institutional Review Board Statement
Informed Consent Statement
Data Availability Statement
Conflicts of Interest
References
- Chinemerem Nwobodo, D.; Ugwu, M.C.; Oliseloke Anie, C.; Al-Ouqaili, M.T.S.; Chinedu Ikem, J.; Victor Chigozie, U.; Saki, M. Antibiotic Resistance: The Challenges and Some Emerging Strategies for Tackling a Global Menace. Clin. Lab. Anal. 2022, 36, e24655. [Google Scholar] [CrossRef] [PubMed]
- Bajalan, A.; Bui, T.; Salvadori, G.; Marques, D.; Schumacher, A.; Rösing, C.K.; Dahle, U.R.; Petersen, F.C.; Ricomini-Filho, A.P.; Nicolau, B.F.; et al. Awareness Regarding Antimicrobial Resistance and Confidence to Prescribe Antibiotics in Dentistry: A Cross-Continental Student Survey. Antimicrob. Resist. Infect. Control 2022, 11, 158. [Google Scholar] [CrossRef]
- Ahmadi, H.; Ebrahimi, A.; Ahmadi, F. Antibiotic Therapy in Dentistry. Int. J. Dent. 2021, 2021, 6667624. [Google Scholar] [CrossRef] [PubMed]
- Koyuncuoglu, C.Z.; Aydin, M.; Kirmizi, N.I.; Aydin, V.; Aksoy, M.; Isli, F.; Akici, A. Rational Use of Medicine in Dentistry: Do Dentists Prescribe Antibiotics in Appropriate Indications? Eur. J. Clin. Pharmacol. 2017, 73, 1027–1032. [Google Scholar] [CrossRef]
- Kelly, S.A.; Rodgers, A.M.; O’Brien, S.C.; Donnelly, R.F.; Gilmore, B.F. Gut Check Time: Antibiotic Delivery Strategies to Reduce Antimicrobial Resistance. Trends Biotechnol. 2020, 38, 447–462. [Google Scholar] [CrossRef] [PubMed]
- Hakim, L.K.; Yazdanian, M.; Alam, M.; Abbasi, K.; Tebyaniyan, H.; Tahmasebi, E.; Khayatan, D.; Seifalian, A.; Ranjbar, R.; Yazdanian, A. Biocompatible and Biomaterials Application in Drug Delivery System in Oral Cavity. Evid. Based Complement. Altern. Med. 2021, 2021, 9011226. [Google Scholar] [CrossRef]
- Niemczyk, W.; Żurek, J.; Niemczyk, S.; Kępa, M.; Zięba, N.; Misiołek, M.; Wiench, R. Antibiotic-Loaded Platelet-Rich Fibrin (AL-PRF) as a New Carrier for Antimicrobials: A Systematic Review of In Vitro Studies. Int. J. Mol. Sci. 2025, 26, 2140. [Google Scholar] [CrossRef]
- Donmezer, C.M.; Bilginaylar, K. Comparison of the Postoperative Effects of Local Antibiotic versus Systemic Antibiotic with the Use of Platelet-Rich Fibrin on Impacted Mandibular Third Molar Surgery: A Randomized Split-Mouth Study. BioMed Res. Int. 2021, 2021, 3040661. [Google Scholar] [CrossRef]
- Prokurat, M.; Grudnik, K.; Niemczyk, W.; Niemczyk, S.; Migas, M.; Wągrowska, K.; Lau, K.; Kasperczyk, J. Platelet-Rich Plasma—A Remedy Present in Every Human Being. History, Functioning, and the Benefits of Therapy Using It. Pol. Merkur. Lek. 2024, 52, 240–245. [Google Scholar] [CrossRef]
- Żurek, J.; Niemczyk, W.; Dominiak, M.; Niemczyk, S.; Wiench, R.; Skaba, D. Gingival Augmentation Using Injectable Platelet-Rich Fibrin (i-PRF)—A Systematic Review of Randomized Controlled Trials. J. Clin. Med. 2024, 13, 5591. [Google Scholar] [CrossRef]
- Zwittnig, K.; Kirnbauer, B.; Jakse, N.; Schlenke, P.; Mischak, I.; Ghanaati, S.; Al-Maawi, S.; Végh, D.; Payer, M.; Zrnc, T.A. Growth Factor Release within Liquid and Solid PRF. J. Clin. Med. 2022, 11, 5070. [Google Scholar] [CrossRef] [PubMed]
- Niemczyk, W.; Niemczyk, S.; Odrzywolska, O.; Doroz, P.; Hochuł, D.; Zawadzka, K. Application of I-PRF in Dentistry. Wiad. Lek. 2024, 77, 2348–2352. [Google Scholar] [CrossRef]
- Miron, R.J.; Chai, J.; Zhang, P.; Li, Y.; Wang, Y.; Mourão, C.F.D.A.B.; Sculean, A.; Fujioka Kobayashi, M.; Zhang, Y. A Novel Method for Harvesting Concentrated Platelet-Rich Fibrin (C-PRF) with a 10-Fold Increase in Platelet and Leukocyte Yields. Clin. Oral Investig. 2020, 24, 2819–2828. [Google Scholar] [CrossRef]
- Chen, X.; Wang, J.; Yu, L.; Zhou, J.; Zheng, D.; Zhang, B. Effect of Concentrated Growth Factor (CGF) on the Promotion of Osteogenesis in Bone Marrow Stromal Cells (BMSC) in Vivo. Sci. Rep. 2018, 8, 5876. [Google Scholar] [CrossRef]
- Li, Z.; Wang, D.; Li, J.; Liu, H.; Nie, L.; Li, C. Bone Regeneration Facilitated by Autologous Bioscaffold Material: Liquid Phase of Concentrated Growth Factor with Dental Follicle Stem Cell Loading. ACS Biomater. Sci. Eng. 2024, 10, 3173–3187. [Google Scholar] [CrossRef] [PubMed]
- İstifli, E.S.; Topaktaş, M. Cytogenetic Genotoxicity of Amoxicillin. Environ. Mol. Mutagen. 2010, 51, 222–228. [Google Scholar] [CrossRef] [PubMed]
- Gouzos, M.; Ramezanpour, M.; Bassiouni, A.; Psaltis, A.J.; Wormald, P.J.; Vreugde, S. Antibiotics Affect ROS Production and Fibroblast Migration in an In-Vitro Model of Sinonasal Wound Healing. Front. Cell. Infect. Microbiol. 2020, 10, 110. [Google Scholar] [CrossRef]
- Tan, E.E.; Quah, S.Y.; Bergenholtz, G.; Rosa, V.; Hoon Yu, V.S.; Tan, K.S. Antibiotics Used in Regenerative Endodontics Modify Immune Response of Macrophages to Bacterial Infection. J. Endod. 2019, 45, 1349–1356. [Google Scholar] [CrossRef]
- Dubey, N.; Xu, J.; Zhang, Z.; Nör, J.E.; Bottino, M.C. Comparative Evaluation of the Cytotoxic and Angiogenic Effects of Minocycline and Clindamycin: An In Vitro Study. J. Endod. 2019, 45, 882–889. [Google Scholar] [CrossRef]
- Duewelhenke, N.; Krut, O.; Eysel, P. Influence on Mitochondria and Cytotoxicity of Different Antibiotics Administered in High Concentrations on Primary Human Osteoblasts and Cell Lines. Antimicrob. Agents Chemother. 2007, 51, 54–63. [Google Scholar] [CrossRef]
- Naal, F.D.; Salzmann, G.M. The Efects of Clindamycin on Human Osteoblasts in Vitro. Arch. Orthop. Trauma Surg. 2008, 128, 317–323. [Google Scholar] [CrossRef] [PubMed]
- Monika, F.; Syaify, A.; Lastianny, S.P. The Influence of Platelet Concentrates with and without Metronidazole Incorporation Pre-Centrifuge towards Periodontal Ligament Fibroblast Proliferation. J. Dentomaxillofac. Sci. 2023, 8, 164–168. [Google Scholar] [CrossRef]
- Egle, K.; Skadins, I.; Grava, A.; Micko, L.; Dubniks, V.; Salma, I.; Dubnika, A. Injectable Platelet-Rich Fibrin as a Drug Carrier Increases the Antibacterial Susceptibility of Antibiotic—Clindamycin Phosphate. Int. J. Mol. Sci. 2022, 23, 7407. [Google Scholar] [CrossRef] [PubMed]
- Serafini, G.; Mariano, A.; Lollobrigida, M.; Lamazza, L.; Mazzucchi, G.; Spigaglia, P.; Barbanti, F.; Scotto d’Abusco, A.; De Biase, A. Advanced Platelet-Rich Fibrin (A-PRF) as Antibiotics Delivery System: In-Vitro Proof-of-Concept Study. Materials 2025, 18, 570. [Google Scholar] [CrossRef] [PubMed]
- Ercan, E.; Suner, S.S.; Silan, C.; Yilmaz, S.; Siddikoglu, D.; Sahiner, N.; Tunali, M. Titanium Platelet–Rich Fibrin (T-PRF) as High-Capacity Doxycycline Delivery System. Clin. Oral Investig. 2022, 26, 5429–5438. [Google Scholar] [CrossRef]
- Wang, S.; Li, Y.; Li, S.; Yang, J.; Tang, R.; Li, X.; Li, L.; Fei, J. Platelet-Rich Plasma Loaded with Antibiotics as an Affiliated Treatment for Infected Bone Defect by Combining Wound Healing Property and Antibacterial Activity. Platelets 2021, 32, 479–491. [Google Scholar] [CrossRef]
- Siawasch, S.A.M.; Andrade, C.; Castro, A.B.; Teughels, W.; Temmerman, A.; Quirynen, M. Impact of Local and Systemic Antimicrobials on Leukocyte- and Platelet Rich Fibrin: An in Vitro Study. Sci. Rep. 2022, 12, 2710. [Google Scholar] [CrossRef]
- Polak, D.; Clemer-Shamai, N.; Shapira, L. Incorporating Antibiotics into Platelet-rich Fibrin: A Novel Antibiotics Slow-release Biological Device. J. Clin. Periodontol. 2019, 46, 241–247. [Google Scholar] [CrossRef]
- Dubnika, A.; Egle, K.; Skrinda-Melne, M.; Skadins, I.; Rajadas, J.; Salma, I. Development of Vancomycin Delivery Systems Based on Autologous 3D Platelet-Rich Fibrin Matrices for Bone Tissue Engineering. Biomedicines 2021, 9, 814. [Google Scholar] [CrossRef]
- Bennardo, F.; Gallelli, L.; Palleria, C.; Colosimo, M.; Fortunato, L.; De Sarro, G.; Giudice, A. Can Platelet-Rich Fibrin Act as a Natural Carrier for Antibiotics Delivery? A Proof-of-Concept Study for Oral Surgical Procedures. BMC Oral Health 2023, 23, 134. [Google Scholar] [CrossRef]
- Walianto, A.P.; Lastianny, S.P.; Hendrawati, H. Bacteria Inhibition of Platelet Concentrates with and without Pre-Centrifugation Metronidazole Incorporation on Aggregatibacter Actinomycetemcomitans. Odonto Dent. J. 2022, 9, 183. [Google Scholar] [CrossRef]
- Straub, A.; Utz, C.; Stapf, M.; Vollmer, A.; Kasper, S.; Kübler, A.C.; Brands, R.C.; Hartmann, S.; Lâm, T.-T. Investigation of Three Common Centrifugation Protocols for Platelet-Rich Fibrin (PRF) as a Bio-Carrier for Ampicillin/Sulbactam: A Prospective Trial. Clin. Oral Investig. 2023, 27, 5991–5998. [Google Scholar] [CrossRef]
- Rodella, L.F.; Favero, G.; Boninsegna, R.; Buffoli, B.; Labanca, M.; Scarì, G.; Sacco, L.; Batani, T.; Rezzani, R. Growth Factors, CD34 Positive Cells, and Fibrin Network Analysis in Concentrated Growth Factors Fraction. Microsc. Res. Tech. 2011, 74, 772–777. [Google Scholar] [CrossRef] [PubMed]
- Lei, L.; Yu, Y.; Han, J.; Shi, D.; Sun, W.; Zhang, D.; Chen, L. Quantification of Growth Factors in Advanced Platelet-rich Fibrin and Concentrated Growth Factors and Their Clinical Efficacy as Adjunctive to the GTR Procedure in Periodontal Intrabony Defects. J. Periodontol. 2020, 91, 462–472. [Google Scholar] [CrossRef]
- Isobe, K.; Watanebe, T.; Kawabata, H.; Kitamura, Y.; Okudera, T.; Okudera, H.; Uematsu, K.; Okuda, K.; Nakata, K.; Tanaka, T.; et al. Mechanical and Degradation Properties of Advanced Platelet-Rich Fibrin (A-PRF), Concentrated Growth Factors (CGF), and Platelet-Poor Plasma-Derived Fibrin (PPTF). Int. J. Implant. Dent. 2017, 3, 17. [Google Scholar] [CrossRef] [PubMed]
- Watanabe, T.; Isobe, K.; Suzuki, T.; Kawabata, H.; Nakamura, M.; Tsukioka, T.; Okudera, T.; Okudera, H.; Uematsu, K.; Okuda, K.; et al. An Evaluation of the Accuracy of the Subtraction Method Used for Determining Platelet Counts in Advanced Platelet-Rich Fibrin and Concentrated Growth Factor Preparations. Dent. J. 2017, 5, 7. [Google Scholar] [CrossRef]
- Chanapiwat, P.; Paiboonvong, T.; Rattanaumpawan, P.; Montakantikul, P. Comparison of the Mathematical Equation and Trapezoidal Approach for 24 h Area under the Plasma Concentration-time Curve Calculation in Patients Who Received Intravenous Vancomycin in an Acute Care Setting. Pharmacol. Res. Perspec. 2023, 11, e01046. [Google Scholar] [CrossRef]
- Pelligand, L.; Møller Sørensen, T.; Cagnardi, P.; Toutain, P.-L.; Allerton, F. Population Pharmacokinetic Meta-Analysis of Five Beta-Lactams Antibiotics to Support Dosing Regimens in Dogs for Surgical Antimicrobial Prophylaxis. Vet. J. 2024, 305, 106136. [Google Scholar] [CrossRef]
- Lončar Brzak, B.; Horvat Aleksijević, L.; Vindiš, E.; Kordić, I.; Granić, M.; Vidović Juras, D.; Andabak Rogulj, A. Osteonecrosis of the Jaw. Dent. J. 2023, 11, 23. [Google Scholar] [CrossRef]
- Tetradis, S.; Allen, M.R.; Ruggiero, S.L. Pathophysiology of Medication-Related Osteonecrosis of the Jaw—A Minireview. JBMR Plus 2023, 7, e10785. [Google Scholar] [CrossRef]
- Mücke, T.; Koerdt, S.; Jung, M.; Mitchell, D.A.; Wolff, K.-D.; Kesting, M.R.; Loeffelbein, D.J. The Role of Mylohyoid Flap in the Treatment of Bisphosphonate-Related Osteonecrosis of the Jaws. J. Cranio-Maxillofac. Surg. 2016, 44, 369–373. [Google Scholar] [CrossRef]
- Straub, A.; Stapf, M.; Fischer, M.; Vollmer, A.; Linz, C.; Lâm, T.-T.; Kübler, A.; Brands, R.C.; Scherf-Clavel, O.; Hartmann, S. Bone Concentration of Ampicillin/Sulbactam: A Pilot Study in Patients with Osteonecrosis of the Jaw. Int. J. Environ. Res. Public Health 2022, 19, 14917. [Google Scholar] [CrossRef] [PubMed]
- Dominiak, M.; Niemczyk, W.; Pitułaj, A.; Świenc, W.; Matys, J. Fatty Degenerative Osteonecrosis of the Jaw: Bridging Molecular Insights and Clinical Practice—A Scoping Review. Int. J. Mol. Sci. 2025, 26, 1853. [Google Scholar] [CrossRef]
- Cano-Duran, J.; Pena-Cardelles, J.; Ortega-Concepcion, D.; Paredes-Rodriguez, V.; Garcia-Riart, M.; Lopez-Quiles, J. The Role of Leucocyte-Rich and Platelet-Rich Fibrin (L-PRF) in the Treatment of the Medication-Related Osteonecrosis of the Jaws (MRONJ). J. Clin. Exp. Dent. 2017, 9, 1051–1059. [Google Scholar] [CrossRef] [PubMed]
- Miranda, M.; Gianfreda, F.; Raffone, C.; Antonacci, D.; Pistilli, V.; Bollero, P. The Role of Platelet-Rich Fibrin (PRF) in the Prevention of Medication-Related Osteonecrosis of the Jaw (MRONJ). BioMed Res. Int. 2021, 2021, 4948139. [Google Scholar] [CrossRef] [PubMed]
- Niemczyk, W.; Matys, J.; Wiench, R.; Żurek, J.; Dominiak, M. The Use of Hyaluronic Acid in the Non-Surgical Treatment of Periodontitis—An Umbrella Review. Biomedicines 2025, 13, 998. [Google Scholar] [CrossRef]
- Pietrzko, M.M.; Pietrzko, M.; Niemczyk, W.; Skaba, D.; Wiench, R. Subgingival Delivery of Statins as an Adjunct in the Non-Surgical Treatment of Periodontitis: A Systematic Review. Biomedicines 2025, 13, 182. [Google Scholar] [CrossRef]
- Niemczyk, W.; Janik, K.; Żurek, J.; Skaba, D.; Wiench, R. Platelet-Rich Plasma and Injectable Platelet-Rich Fibrin (i-PRF) in the Non-Surgical Treatment of Periodontitis—A Systematic Review. Int. J. Mol. Sci. 2024, 25, 6319. [Google Scholar] [CrossRef]
- Thamaraiselvan, M.; Jayakumar, N.D. Efficacy of Injectable Platelet Rich Fibrin (i-PRF) as Novel Vehicle for Local Drug Delivery (LDD) in Non-Surgical Periodontal Pocket Therapy—A Randomised Controlled Clinical Trial. J. Adv. Periodontol. Implant. Dent. 2024, 16, 94–102. [Google Scholar] [CrossRef]
- Eastham, J.E.; Seymour, R.A. Local Drug Delivery in the Management of Periodontal Diseases Part 2: Specific Agents. Dent. Update 2014, 41, 796–810. [Google Scholar] [CrossRef]
- Sgolastra, F.; Severino, M.; Petrucci, A.; Gatto, R.; Monaco, A. Effectiveness of Metronidazole as an Adjunct to Scaling and Root Planing in the Treatment of Chronic Periodontitis: A Systematic Review and Meta-analysis. J. Periodontal Res. 2014, 49, 10–19. [Google Scholar] [CrossRef]
- Zandbergen, D.; Slot, D.E.; Cobb, C.M.; Van Der Weijden, F.A. The Clinical Effect of Scaling and Root Planing and the Concomitant Administration of Systemic Amoxicillin and Metronidazole: A Systematic Review. J. Periodontol. 2013, 84, 332–351. [Google Scholar] [CrossRef] [PubMed]
- Miani, P.K.; Nascimento, C.; Sato, S.; Filho, A.V.; Fonseca, M.J.V.; Pedrazzi, V. In Vivo Evaluation of a Metronidazole-Containing Gel for the Adjuvant Treatment of Chronic Periodontitis: Preliminary Results. Eur. J. Clin. Microbiol. Infect. Dis. 2012, 31, 1611–1618. [Google Scholar] [CrossRef] [PubMed]
- Schwendicke, F.; Frencken, J.E.; Bjørndal, L.; Maltz, M.; Manton, D.J.; Ricketts, D.; Van Landuyt, K.; Banerjee, A.; Campus, G.; Doméjean, S.; et al. Managing Carious Lesions: Consensus Recommendations on Carious Tissue Removal. Adv. Dent. Res. 2016, 28, 58–67. [Google Scholar] [CrossRef] [PubMed]
- Niemczyk, W.; Balicz, A.; Lau, K.; Morawiec, T.; Kasperczyk, J. Factors Influencing Peri-Extraction Anxiety: A Cross-Sectional Study. Dent. J. 2024, 12, 187. [Google Scholar] [CrossRef]
- Calvo, A.M.; Brozoski, D.T.; Giglio, F.P.M.; Gonçalves, P.Z.; Sant’ana, E.; Dionísio, T.J.; Lauris, J.R.P.; Santos, C.F. Are Antibiotics Necessary after Lower Third Molar Removal? Oral Surg. Oral Med. Oral Pathol. Oral Radiol. 2012, 114, S199–S208. [Google Scholar] [CrossRef]
- Kaczmarzyk, T.; Babiuch, K.; Bołtacz-Rzepkowska, E.; Dominiak, M.; Konopka, T.; Lipski, M.; Olczak-Kowalczyk, D.; Szeląg, A.; Szuta, M.; Hryniewicz, W. Polish Dental Association And National Programme To Protect Antibiotics Working Group Recommendations for Administration of Antibiotics in Dentistry. J. Stomatol. 2018, 71, 457–465. [Google Scholar] [CrossRef]
- Arora, A.; Roychoudhury, A.; Bhutia, O.; Pandey, S.; Singh, S.; Das, B.K. Antibiotics in Third Molar Extraction; Are They Really Necessary: A Non-Inferiority Randomized Controlled Trial. Natl. J. Maxillofac. Surg. 2014, 5, 166–171. [Google Scholar] [CrossRef]
- Ramos, E.; Santamaría, J.; Santamaría, G.; Barbier, L.; Arteagoitia, I. Do Systemic Antibiotics Prevent Dry Socket and Infection after Third Molar Extraction? A Systematic Review and Meta-Analysis. Oral Surg. Oral Med. Oral Pathol. Oral Radiol. 2016, 122, 403–425. [Google Scholar] [CrossRef]
- Balakrishnan, G.; Narendar, R.; Kavin, T.; Venkataraman, S.; Gokulanathan, S. Incidence of Trismus in Transalveolar Extraction of Lower Third Molar. J. Pharm. Bioall Sci. 2017, 9, 222. [Google Scholar] [CrossRef]
- Mariscal-Cazalla, M.D.M.; Manzano-Moreno, F.J.; García-Vázquez, M.; Vallecillo-Capilla, M.F.; Olmedo-Gaya, M.V. Do Perioperative Antibiotics Reduce Complications of Mandibular Third Molar Removal? A Double-Blind Randomized Controlled Clinical Trial. Oral Surg. Oral Med. Oral Pathol. Oral Radiol. 2021, 131, 286–294. [Google Scholar] [CrossRef] [PubMed]
- Sologova, D.; Diachkova, E.; Gor, I.; Sologova, S.; Grigorevskikh, E.; Arazashvili, L.; Petruk, P.; Tarasenko, S. Antibiotics Efficiency in the Infection Complications Prevention after Third Molar Extraction: A Systematic Review. Dent. J. 2022, 10, 72. [Google Scholar] [CrossRef] [PubMed]
- Sohn, D.-S.; Heo, J.-U.; Kwak, D.-H.; Kim, D.-E.; Kim, J.-M.; Moon, J.-W.; Lee, J.-H.; Park, I.-S. Bone Regeneration in the Maxillary Sinus Using an Autologous Fibrin-Rich Block With Concentrated Growth Factors Alone. Implant. Dent. 2011, 20, 389–395. [Google Scholar] [CrossRef] [PubMed]
- Mourão, C.F.D.A.B.; Valiense, H.; Melo, E.R.; Mourão, N.B.M.F.; Maia, M.D.-C. Obtention of Injectable Platelets Rich-Fibrin (i-PRF) and Its Polymerization with Bone Graft: Technical Note. Rev. Col. Bras. Cir. 2015, 42, 421–423. [Google Scholar] [CrossRef]
- Gheno, E.; Alves, G.G.; Ghiretti, R.; Mello-Machado, R.C.; Signore, A.; Lourenço, E.S.; Leite, P.E.C.; Mourão, C.F.D.A.B.; Sohn, D.-S.; Calasans-Maia, M.D. “Sticky Bone” Preparation Device: A Pilot Study on the Release of Cytokines and Growth Factors. Materials 2022, 15, 1474. [Google Scholar] [CrossRef]

| Bacteria Strain | APC | Time of Measurement | Group 1 | Group 2 | Group 3 | Group 4 | Group 5 | Group 6 |
|---|---|---|---|---|---|---|---|---|
| S. aureus (MSSA) | c-PRF | 20 h | - | 41.07 (±0.13) | 43.86 (±0.10) | - | 41.86 (±0.41) | 44.25 (±0.08) * |
| 40 h | - | 16.55 (±0.64) | 21.76 (±0.10) | 7.16 (±0.03) * | 20.51 (±0.69) * | 22.58 (±0.38) | ||
| 60 h | - | - | - | - | 6.97 (±0.03) * | 7.02 (±0.04) * | ||
| 80 h | - | - | - | - | - | - | ||
| LPCGF | 20 h | - | 40.32 (±0.48) | 44.67 (±0.39) | - | 41.24 (±0.43) | 45.51 (±0.46) | |
| 40 h | - | 17.52 (±0.38) | 22.33 (±0.11) | 7.21 (±0.11) | 17.86 (±0.32) | 22.85 (±0.34) | ||
| 60 h | - | - | - | - | - | - | ||
| MRSA | c-PRF | 20 h | - | 16.27 (±0.13) | 20.46 (±0.46) | - | 17.10 (±0.42) | 23.43 (±0.29) * |
| 40 h | - | - | - | - | - | - | ||
| LPCGF | 20 h | - | 20.16 (±0.17) | 23.01 (±0.4) | - | 22.03 (±0.15) * | 23.44 (±0.24) | |
| 40 h | - | - | - | - | - | - | ||
| E. faecalis | c-PRF | 20 h | - | 32.02 (±0.10) | 35.74 (±0.10) | - | 34.08 (±0.17) * | 36.29 (±0.16) * |
| 40 h | - | 15.96 (±0.07) | 20.36 (±0.11) | - | 17.39 (±0.12) * | 20.72 (±0.11) | ||
| 60 h | - | - | - | - | - | - | ||
| LPCGF | 20 h | - | 36.04 (±0.16) | 36.21 (±0.22) | - | 36.13 (±0.16) | 20.97 (±0.58) | |
| 40 h | - | 17.60 (±0.28) | 20.34 (±0.19) | - | 18.75 (±0.47) | 20.48 (±0.29) | ||
| 60 h | - | - | - | - | - | - |
| Bacteria Strain | APC | Time of Measurement | Group 1 | Group 2 | Group 3 | Group 4 | Group 5 | Group 6 |
|---|---|---|---|---|---|---|---|---|
| S. aureus (MSSA) | c-PRF | 20 h | - | 24 (±0.08) | 28.96 (±0.06) | - | 30.38 (±0.43) * | 32.15 (±0.07) * |
| 40 h | - | - | - | 7.07 (±0.02) * | 12.96 (±0.08) * | 13.05 (±0.32) * | ||
| 60 h | - | - | - | - | - | - | ||
| LPCGF | 20 h | - | 24.26 (±0.20) | 28.54 (±0.49) | - | 30.19 (±0.14) * | 31.18 (±0.15) | |
| 40 h | - | - | - | 7.97 (±0.34) * | 13.79 (±0.29) * | 14.46 (±0.46) * | ||
| 60 h | - | - | - | - | - | - | ||
| MRSA | c-PRF | 20 h | - | 15.32 (±0.31) | 20.66 (±0.15) | - | 21.38 (±0.36) * | 21.40 (±0.40) |
| 40 h | - | - | - | - | - | - | ||
| LPCGF | 20 h | - | 16.67 (±0.75) | 20.65 (±0.24) | - | 19.38 (±0.59) | 20.97 (±0.58) | |
| 40 h | - | - | - | - | - | - | ||
| E. faecalis | c-PRF | 20 h | - | 7.29 (±0.33) | 7.26 (±0.05) | - | 7.32 (±0.32) | 7.26 (±0.06) |
| 40 h | - | - | - | - | - | - | ||
| LPCGF | 20 h | - | 6.56 (±0.31) | 6.96 (±0.13) | - | 7.04 (±0.04) | 7.12 (±0.02) | |
| 40 h | - | - | - | - | - | - |
| Bacteria Strain | APC | Time of Measurement | Group 1 | Group 2 | Group 3 | Group 4 | Group 5 | Group 6 |
|---|---|---|---|---|---|---|---|---|
| S. aureus (MSSA) | c-PRF | 20 h | - | 41.50 (±0.15) | 45.77 (±0.04) | - | 41.90 (±0.12) | 46.11 (±0.12) |
| 40 h | - | 19.05 (±0.27) | 24.04 (±0.07) | 8.07 (±0.18) * | 19.66 (±0.12) | 24.11 (±0.21) | ||
| 60 h | - | - | - | - | 6.40 (±0.70) | 7.16 (±0.02) * | ||
| 80 h | - | - | - | - | - | - | ||
| LPCGF | 20 h | - | 41.13 (±0.15) | 44.59 (±0.33) | - | 41.42 (±0.05) | 46.24 (±0.10) | |
| 40 h | - | 18.98 (±0.15) | 23.33 (±0.21) | 7.05 (±0.15) | 19.43 (±0.25) | 25.02 (±0.34) | ||
| 60 h | - | - | - | - | - | 7.05 (±0.11) | ||
| 80 h | - | - | - | - | - | - | ||
| MRSA | c-PRF | 20 h | - | 17.05 (±0.07) | 21.01 (±0.13) | - | 17.09 (±0.05) | 21.09 (±0.11) |
| 40 h | - | - | - | - | - | - | ||
| LPCGF | 20 h | - | 16.81 (±0.28) | 21.01 (±0.20) | - | 17.42 (±0.26) | 22.25 (±0.74) | |
| 40 h | - | - | - | - | - | - | ||
| E. faecalis | c-PRF | 20 h | - | 31.89 (±0.32) | 33.37 (±0.23) | - | 32.14 (±0.19) | 33.41 (±0.50) |
| 40 h | - | 15.00 (±0.22) | 19.73 (±0.35) | - | 15.41 (±0.42) | 19.92 (±0.26) | ||
| 60 h | - | - | - | - | - | - | ||
| LPCGF | 20 h | - | 31.96 (±0.23) | 34.17 (±0.59) | - | 32.01 (±0.23) | 35.00 (±0.80) | |
| 40 h | - | 14.95 (±0.25) | 19.69 (±0.41) | - | 15.12 (±0.53) | 20.82 (±0.38) | ||
| 60 h | - | - | - | - | - | - |
| Inclusion Criteria: | Exclusion Criteria: |
|---|---|
|
|
| Drug Incorporated into APC | Amount of Drug Added per mL of APC (c-PRF/LPCGF) | Concentration of Drug in APC |
|---|---|---|
| Amoxicillin with clavulanic acid (Amoksiklav® 500 mg + 100 mg) | 0.1 mL (5 mg + 1 mg) | 0.05 mg/mL |
| 0.25 mL (12.5 mg + 2.5 mg) | 0.12 mg/mL | |
| Clindamycin (Clindamycin-MIP® 150 mg/mL) | 0.1 mL (15 mg) | 0.14 mg/mL |
| 0.25 mL (37.5 mg) | 0.3 mg/mL | |
| Amoxicillin with clavulanic acid + Metronidazole (Amoksiklav® 500 mg + 100 mg + Metronidazole Braun® 5 mg/mL) | 0.1 mL (5 mg + 1 mg) AMX + 0.5 mg MET | 0.05 mg/mL AMX + 0.003 mg/mL MET |
| 0.25 mL (12.5 mg + 2.5 mg) AMX + 1.25 mg MET | 0.12 mg/mL AMX + 0.01 mg/mL MET |
| Bacterial Strain | Culture Media | ATCC Number |
|---|---|---|
| Staphylococcus aureus MRSA | Mueller–Hinton agar | 43300 |
| Staphylococcus aureus MSSA | Mueller–Hinton agar | 25923 |
| Enterococcus faecalis | Mueller–Hinton agar | 29212 |
Disclaimer/Publisher’s Note: The statements, opinions and data contained in all publications are solely those of the individual author(s) and contributor(s) and not of MDPI and/or the editor(s). MDPI and/or the editor(s) disclaim responsibility for any injury to people or property resulting from any ideas, methods, instructions or products referred to in the content. |
© 2025 by the authors. Licensee MDPI, Basel, Switzerland. This article is an open access article distributed under the terms and conditions of the Creative Commons Attribution (CC BY) license (https://creativecommons.org/licenses/by/4.0/).
Share and Cite
Niemczyk, W.; Kępa, M.; Żurek, J.; Aboud, A.; Skaba, D.; Wiench, R. Comparative Evaluation of Platelet-Rich Fibrin (PRF) and Concentrated Growth Factor (CGF) as Carriers for Antibiotics—In Vitro Study. Int. J. Mol. Sci. 2025, 26, 4303. https://doi.org/10.3390/ijms26094303
Niemczyk W, Kępa M, Żurek J, Aboud A, Skaba D, Wiench R. Comparative Evaluation of Platelet-Rich Fibrin (PRF) and Concentrated Growth Factor (CGF) as Carriers for Antibiotics—In Vitro Study. International Journal of Molecular Sciences. 2025; 26(9):4303. https://doi.org/10.3390/ijms26094303
Chicago/Turabian StyleNiemczyk, Wojciech, Małgorzata Kępa, Jacek Żurek, Ali Aboud, Dariusz Skaba, and Rafał Wiench. 2025. "Comparative Evaluation of Platelet-Rich Fibrin (PRF) and Concentrated Growth Factor (CGF) as Carriers for Antibiotics—In Vitro Study" International Journal of Molecular Sciences 26, no. 9: 4303. https://doi.org/10.3390/ijms26094303
APA StyleNiemczyk, W., Kępa, M., Żurek, J., Aboud, A., Skaba, D., & Wiench, R. (2025). Comparative Evaluation of Platelet-Rich Fibrin (PRF) and Concentrated Growth Factor (CGF) as Carriers for Antibiotics—In Vitro Study. International Journal of Molecular Sciences, 26(9), 4303. https://doi.org/10.3390/ijms26094303

